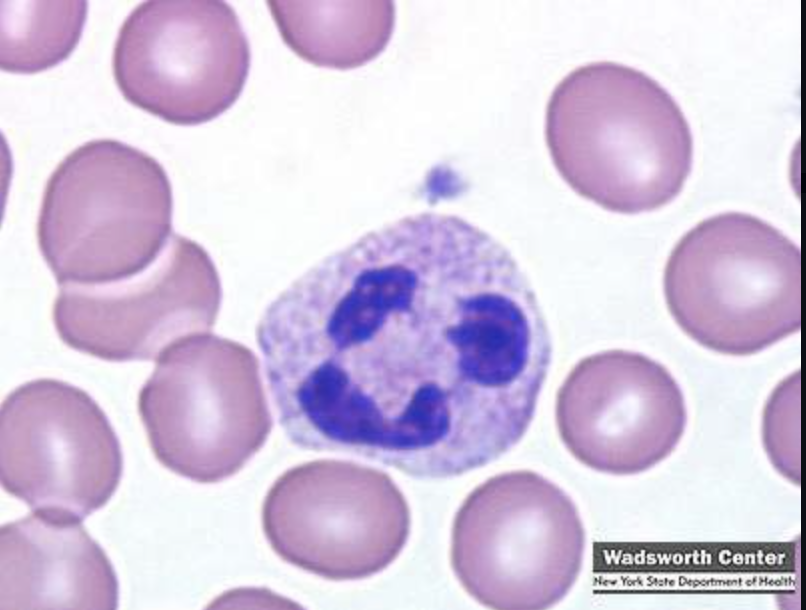
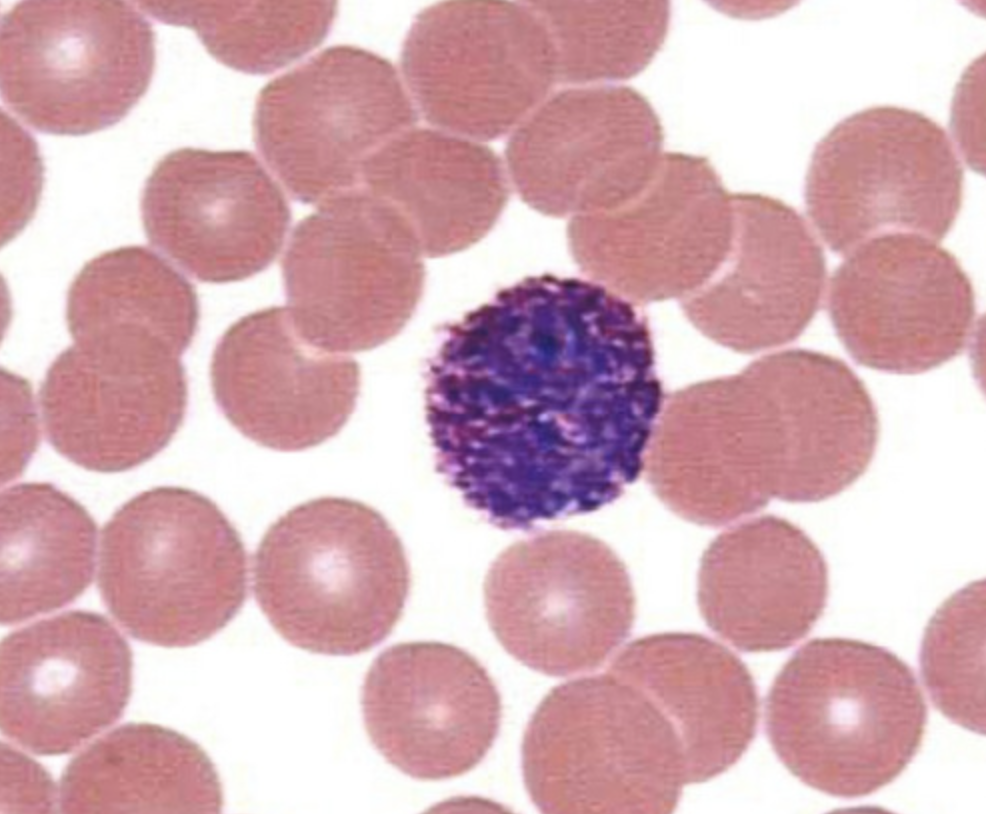
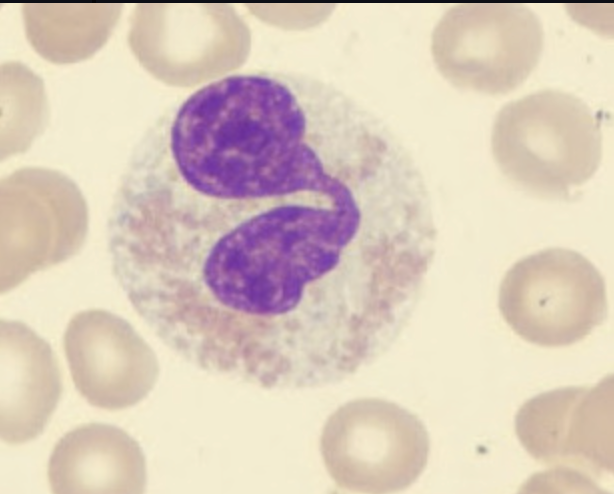
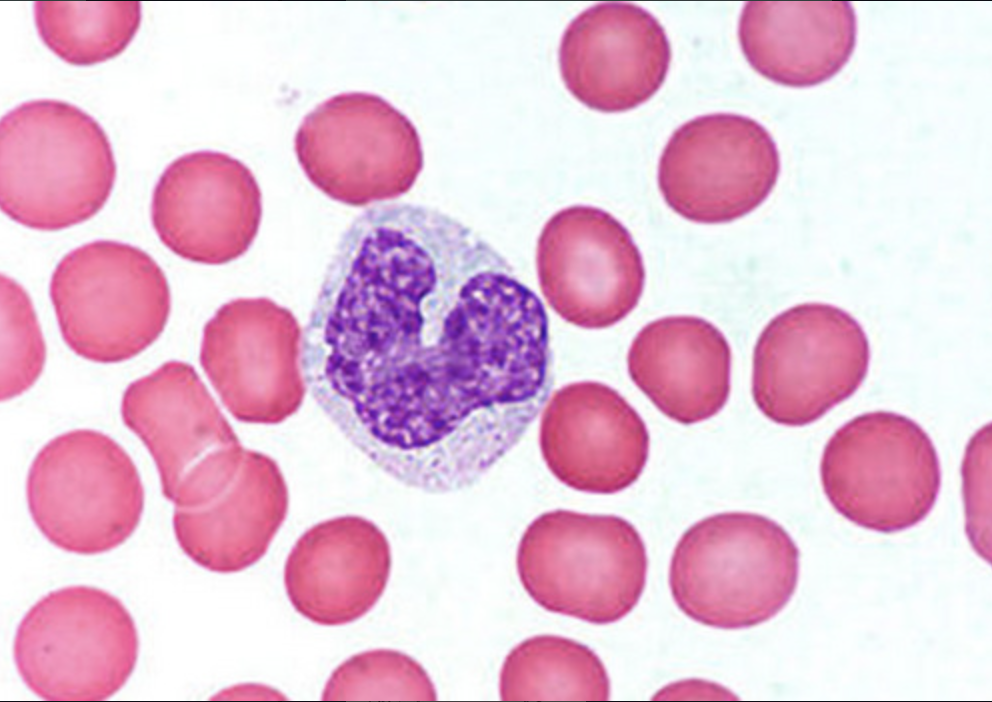

Immunity that is present before exposure and effective from birth. Responds to a broad range of pathogens.
innate (natural) immunity
- skin
- mucous membranes and their secretions
- normal microbiota
first line of defense of immunity
- phagocytes
- inflammation
- fever
- antimicrobials
second line of defense of immunity
- specialized lymphocytes (T and B cells)
- antibodies
third line of defense of immunity
The first and second line of defense of immunity is considered ____ immunity
innate
The third line of defense of immunity is considered ____ immunity
adaptive
A cell within the body can engulf and absorb bacteria and other small cells and particles.
Phagocytes
examples of phagocytes (2)
macrophages and neutrophils
the ability to recognize and remember specific antigens and mount an attack on them
adaptive (acquired) immunity
The third line of defense is made up of ____ and ____ immunity
humoral / cellular
ability to ward off disease
immunity
lack of resistance to a disease
susceptibility
defenses against any pathogen; rapid, present at birth
innate immunity
immunity or resistance to a specific pathogen; slower to respond, has memory component
adaptive immunity
blood cell formation; process begins in red bone marrow with a pluripotent stem cell

Hematopoiesis
white blood cells, fight infection
Leukocytes
3 types of leukocytes
neutrophils, eosinophils, basophils
A type of white blood cell that engulfs invading microbes and contributes to the nonspecific defenses of the body against disease.
Function: phagocytosis
Neutrophils
A circulating leukocyte that produces histamine.
Basophils
leukocyte that produces toxic proteins against certain parasites
Eosinophils
An agranular leukocyte is able to migrate into tissues and transform into a macrophage.
Monocytes
An agranular leukocyte that performs phagocytosis and initiation of adaptive immunity responses
dendritic cells
A type of white blood cell that make antibodies to fight off infections
Lymphocytes
2 types of lymphocytes
B cells & T cells











